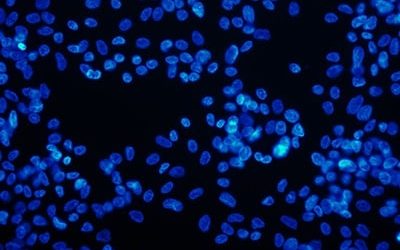
ICC
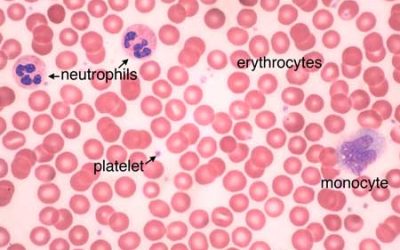
BIOLOGY

خدمات بافت شناسی، مهندسی بافت و رنگ آمیزی های پاتولوژی
- تهیه مقاطع بافتی پارافینی و فروزن در اندازه های مختلف
- تمامی رنگ آمیزی های عمومی و اختصاصی بافت و سلول
- انجام تکنیک ایمونوسیتوشیمی (ICC)
- انجام تکنیک ایمونوهیستوشیمی (IHC)
- انجام تکنیک تانل جهت بررسی آپوپتوز
- تهیه مقاطع از داربست های بافتی شیمیایی و طبیعی
- آماده سازی لام های آموزشی از تمام بافت های موجود
- بررسی قرارگیری سلول بر روی داربست های بافتی با میکروسکوپ SEM
- تهیه مقاطع بافتی جهت بررسی با میکروسکوپ TEM

روش های بافتشناسی، از ابتدای پذیرش نمونه در آزمایشگاه پاتولوژی تا آماده سازی لام و بررسی آن در زیر میکروسکوپ که شامل مراحل فیکساسیون، قالبگیری، برش با میکروتوم، رنگآمیزی و مونتاژ لام و لامل را شامل می شود.
از طرفی در علوم جدیدی همچون مهندسی بافت، به کارگیری تکنیک های به روز آماده سازی مقاطع و ردیابی سلولی و ساختار بافتی مهندسی شده، کمک چشمگیری در پیشرفت این علوم داشته است.